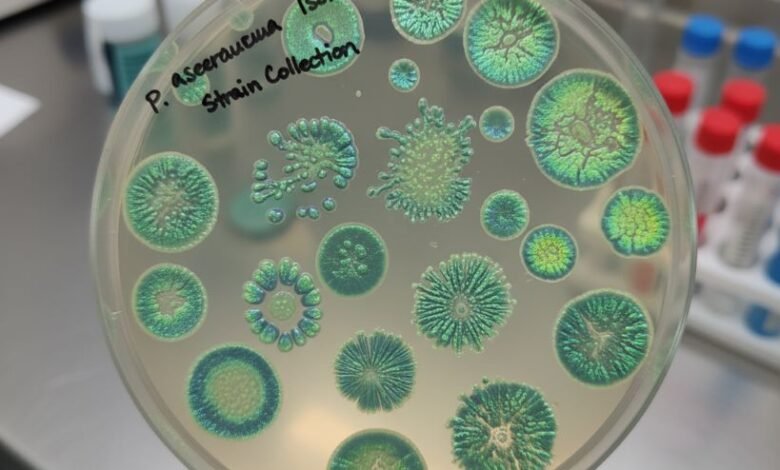
pseudomonas aeruginosa isloates

Infectious Diseases
-

Pseudomonas aeruginosa in hospitalized patients – A Saudi Arabian study on resistance patterns and virulence factors
Pseudomonas aeruginosa is categorized by global health authorities as a “critical” pathogen due to its increasing propensity for antibiotic resistance. It is a significant cause of severe healthcare-associated infections, including ventilator-associated pneumonia and bloodstream infections, especially in critically ill patients. A recent retrospective observational study conducted at King Khalid Hospital in Saudi Arabia and published in Nature Scientific Reports analyzed…
Read More » -

Epidemiology and seasonality of respiratory syncytial virus in the UAE. A five-year (2018-2022) study at Tawam Hospital
Respiratory Syncytial Virus (RSV) remains a chief cause of severe lower respiratory tract infections and subsequent hospital admissions among infants and young children worldwide. Understanding its local transmission patterns is vital for implementing timely and effective preventative measures, such as monoclonal antibody prophylaxis. Historically, RSV exhibits a predictable seasonal pattern, but the COVID-19 pandemic and associated non-pharmaceutical interventions (NPIs)—like physical…
Read More » -

Evolving Challenges in Combating Invasive Pneumococcal Disease in the Gulf Region
Invasive pneumococcal disease (IPD), caused by Streptococcus pneumoniae, remains a major public health concern across the Gulf Cooperation Council (GCC) nations, disproportionately affecting vulnerable groups such as young children and individuals with chronic illnesses. A narrative review summarizing data from Bahrain, Kuwait, Oman, Qatar, Saudi Arabia, and the United Arab Emirates (UAE) highlights the varied epidemiology, the continued disease burden,…
Read More » -

Clarithromycin-loaded Nanoparticles Enhance Antibacterial and Anticancer Performance
Researchers have successfully developed clarithromycin-loaded albumin-based nanoparticles (CLA-BSA NPs) that promise to revolutionize the delivery of antibacterial and anticancer drugs. This innovative drug delivery system, detailed in a study published in Pharmaceutics on May 31, 2025, showcases enhanced therapeutic efficacy for clarithromycin, a widely used antibiotic already known for its diverse medical applications. Clarithromycin (CLA) is a broad-spectrum antibiotic commonly…
Read More »